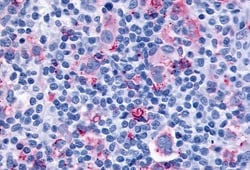

Promotional price valid on web orders only. Your contract pricing may differ. Interested in signing up for a dedicated account number?
Learn More
Learn More
Invitrogen™ CYSLTR1 Polyclonal Antibody


Rabbit Polyclonal Antibody
Supplier: Invitrogen™ PA533464
Description
Percent identity with other species by BLAST analysis: Human, Gorilla (100%) Monkey, Marmoset (95%) Gibbon, Mouse, Panda (90%) Rat, Bovine, Elephant, Rabbit, Pig (85%).
The cysteinyl leukotrienes LTC4, LTD4, and LTE4 are important mediators of human bronchial asthma. Pharmacologic studies have determined that cysteinyl leukotrienes activate at least 2 receptors, the protein encoded by this gene and CYSLTR2. This encoded receptor is a member of the superfamily of G protein-coupled receptors. Activation of this receptor by LTD4 results in contraction and proliferation of smooth muscle, oedema, eosinophil migration and damage to the mucus layer in the lung.
Specifications
| CYSLTR1 | |
| Polyclonal | |
| Unconjugated | |
| CYSLTR1 | |
| BB147369; CysLT 1; CysLT(1); Cyslt1; CysLT1 receptor; Cys-LT1 receptor; Cyslt1r; CYSLTR; Cysltr1; cysteinyl leukotriene 1 receptor short isoform; cysteinyl leukotriene D4 receptor; Cysteinyl leukotriene receptor 1; G-protein coupled receptor HG55; HG55; HMTMF81; LTD4 receptor; LTD4R; MGC46139 | |
| Rabbit | |
| Antigen affinity chromatography | |
| RUO | |
| 10800 | |
| Store at 4°C short term. For long term storage, store at -20°C, avoiding freeze/thaw cycles. | |
| Liquid |
| Immunohistochemistry (Paraffin) | |
| 1 mg/mL | |
| PBS with 0.1% sodium azide | |
| Q9Y271 | |
| CYSLTR1 | |
| Synthetic 20 amino acid peptide from C-terminus of human CYSLTR1 / CYSLT1. | |
| 50 μg | |
| Primary | |
| Human | |
| Antibody | |
| IgG |
Safety and Handling
WARNING: Cancer - www.P65Warnings.ca.gov
Product Content Correction
Your input is important to us. Please complete this form to provide feedback related to the content on this product.
Product Title
Spot an opportunity for improvement?Share a Content Correction